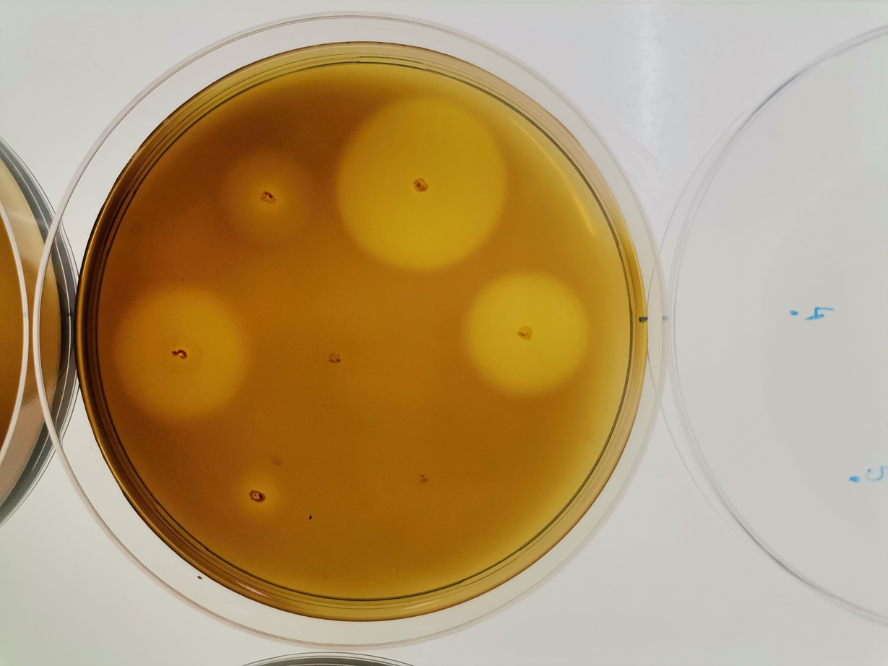
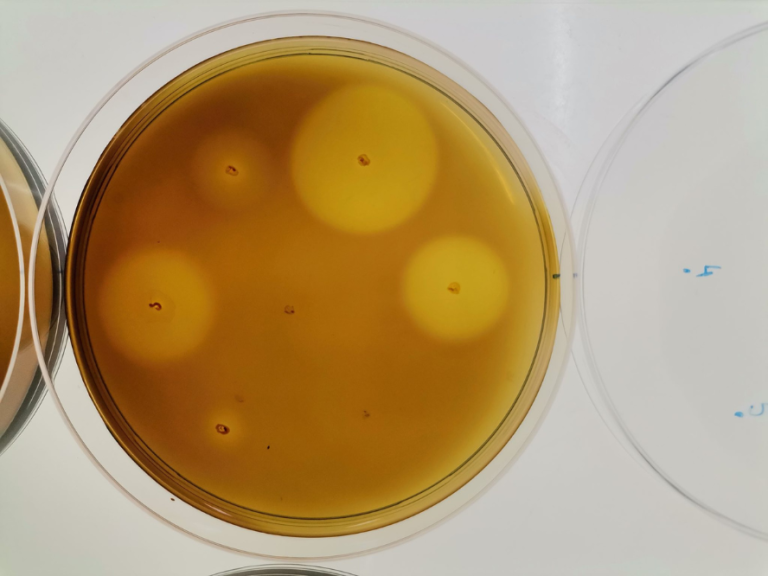

Od gena do leka: kako mikroorganizmi inspirišu biotehnološke inovacije
Kako mikroorganizmi mogu da pomognu u borbi protiv bakterijskih infekcija? Na ovoj radionici otkrićete kako istraživanja u oblasti biotehnologije povezuju genetiku, prirodu i tehnologiju, stvarajući temelje za razvoj novih terapija i inovativnih biotehnoloških rešenja.
O ovoj radionici
O predavaču
Radionicu vodi Marija Atanasković, istraživač saradnik na Institutu za molekularnu genetiku i genetičko inženjerstvo. Bavi se biotehnologijom i pronalaženjem novih enzima iz prirodnih izvora koji se mogu primeniti u lečenju bakterijskih infekcija. Enzimi sa kojima radi razgrađuju komponente matriksa bakterijskih biofilmova ili sprečavaju komunikaciju između bakterija, čime doprinose razvoju novih pristupa u medicini.
Šta ćete naučiti
Radionica kombinuje biologiju, biotehnologiju i preduzetništvo kroz praktične primere iz istraživačkog rada predavača. Učesnici će saznati kako se geni za nove enzime pronalaze u prirodi, kako se ispituju i optimizuju, kao i kako se rezultati istraživanja mogu primeniti u medicini ili industriji. U interaktivnom delu, učesnici će naučiti da koriste online bioinformatičke alate za analizu potencijalnih novih enzima i diskutovati o idejama za njihovu primenu.
Zašto se prijaviti?
Ova radionica je prilika da iz prve ruke otkrijete kako multidisciplinarni pristup povezuje nauku, kreativnost i preduzetništvo. Kroz primere iz savremene biotehnologije, naučićete kako radoznalost vodi do inovacije — i kako istraživanja iz laboratorije mogu postati rešenja koja menjaju svet.